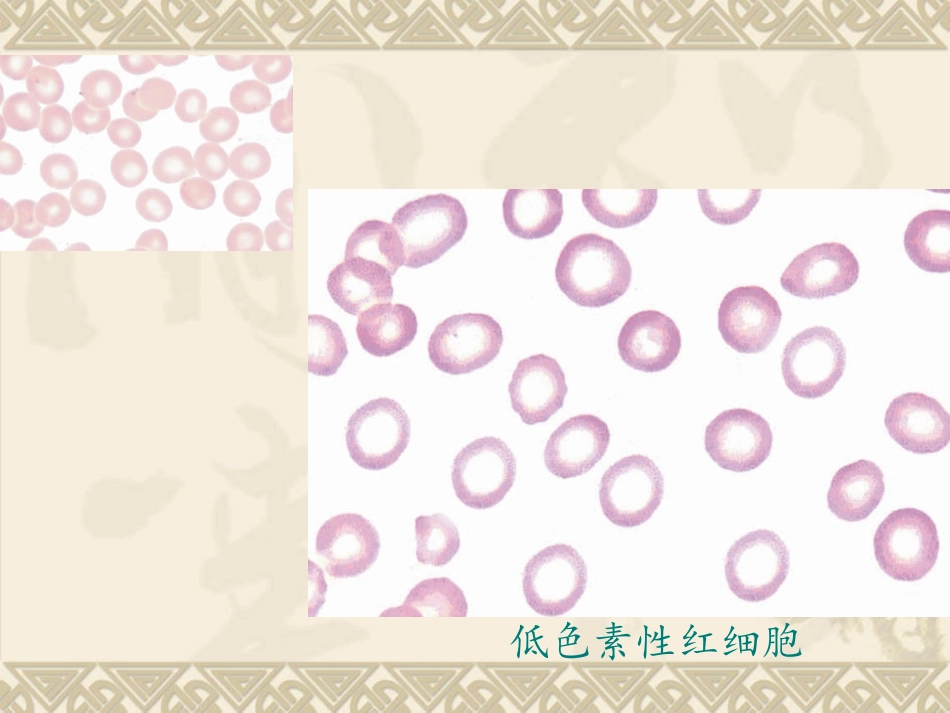
人体白细胞检查_第2页

实验诊断学---白细胞检查低色素性红细胞白细胞起源于骨髓的造血干细胞(HSC),在骨髓多种造血生长因子的调控下,最终分化、发育、成熟并释放到外周血液
白细胞概述白细胞计数白细胞计数是指测定单位容积的外周血液中白细胞总数
成人:(4~10)×109/L;儿童:(5~12)×109/L;6个月~2岁:(11~12)×109/L;新生儿:(15~20)×109/L
白细胞分类计数【检测原理】将血液制备成血涂片,经Wright染色后,在油镜下,观察染色后血涂片上白细胞的形态,并进行分类计数,以求得各种白细胞的比值(百分率)和绝对值
(绝对值=白细胞计数值×该种白细胞分类计数的百分率)杆状核嗜酸嗜碱淋巴单核分叶核白细胞分类计数参考值中性粒细胞异常数量异常核象异常形态异常数量减少数量增加核右移核左移巨分叶核中毒性改变棒状小体中性粒细胞病理性增多的原因很多,大致上可归纳为两大类:反应性增多和异常增生性增多
反应性增多:是机体对各种病理因素刺激产生应激反应,动员骨髓贮存池的粒细胞释放及(或)边缘池的粒细胞进入循环池所致
中性粒细胞增多中性粒细胞反应性增多急性感染严重组织损伤、大手术:鉴别心梗(增高)及心绞痛(正常)急性溶血急性大出血(高达20X109/L)急性中毒消化道肿瘤异常增生性增多:系造血干细胞克隆性疾病,为造血组织中粒细胞大量异常增生并释放到外周血液所致,增多的粒细胞主要是病理性粒细胞或未成熟粒细胞,常伴其他细胞改变,如红细胞或血小板增多或减少
(急性粒细胞白血病和慢性粒细胞白血病)
白细胞总数<4x109白细胞减少中性粒细胞<1
5x109粒细胞减少中性粒细胞<0
5x109粒细胞缺乏中性粒细胞减少中性粒细胞异常数量异常核象异常形态异常数量减少数量增加核右移核左移巨分叶核中毒性改变棒状小体核左移:核左移:外周血中杆状核粒细胞增多并出现晚幼粒、中幼粒甚至早幼